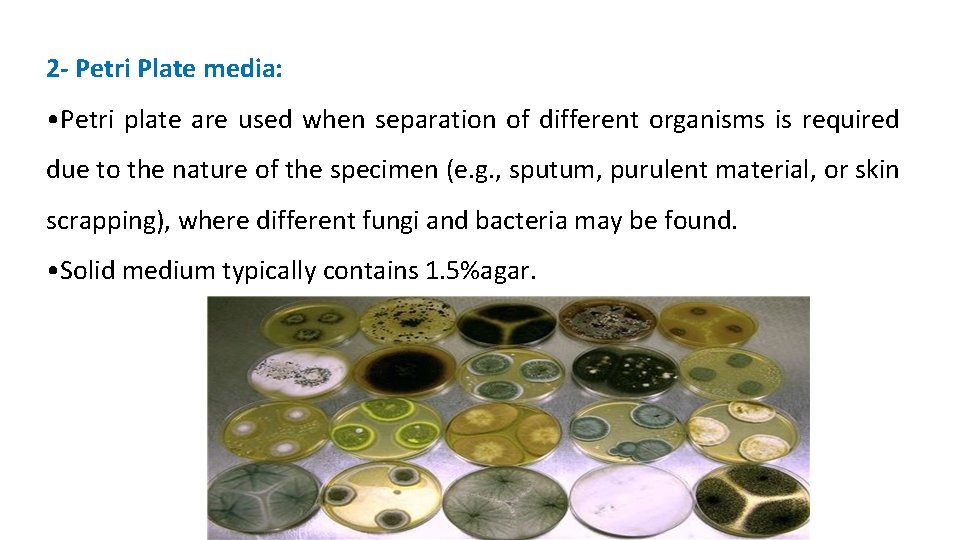
2 - Petri Plate media: • Petri plate are used when separation of different

Practical medical mycology Lab 3 Fungal culture isolation

ﺑﺴﻢ ﺍﻟﻠﻪ ﺍﻟﺮﺣﻤﻦ ﺍﻟﺮﺣﻴﻢ Practical medical mycology Lab 3 Fungal culture isolation and other techniques

Common methods for cultivation of fungi 1 - Tube media: • The use of tube media rather than petri dishes is preferable when specimens are obtained from sterile sites and contamination is not expected. • Tubes should have a relatively large diameter, such as 18 x 150 mm, and contain a thick butt of medium that will not readily become dry.
2 - Petri Plate media: • Petri plate are used when separation of different organisms is required due to the nature of the specimen (e. g. , sputum, purulent material, or skin scrapping), where different fungi and bacteria may be found. • Solid medium typically contains 1. 5%agar.

Types of culture media • Sabouraud's dextrose agar - is a selective medium primarily used for the isolation of dermatophytes, other fungi and yeasts but can also grow filamentous bacteria such as Nocardia. Composition of media Ingredients Gm/L Mycological peptone (enzymatic digest of casein and animal tissues) 10 gm Dextrose 40 gm Agar 15 gm p. H adjust to 5. 6 at 250 C

Principle • The SDA media is comprised of enzymatic digest of casein and animal tissues which provide a nutritious source of amino acids and nitrogenous compounds for the growth of fungi and yeasts. • Dextrose is a carbon and energy source, Agar is the solidifying agent. • Addition of antibiotics like Chloramphenicol and/or tetracycline acts as broad spectrum antimicrobials to inhibit the growth of a wide range of gram-positive and gramnegative bacteria. • Gentamicin is added to further inhibit the growth of gram-negative bacteria. • The acidic p. H of this medium (p. H about 5. 0) inhibits the growth of bacteria but permits the growth of yeasts and most filamentous fungi.

• Mycosel agar: a commercially produced agar containing chloramphenicol to inhibit bacterial growth, and cycloheximide to inhibit saprophytic fungi and some yeasts (including C. neoformans). • Composition of media Ingredients Gm/L Papaic Digest of Soybean Meal 10 gm Dextrose 10 gm Agar 15. 5 gm Chloramphenicol 0. 05 g Cycloheximide 0. 4 g

• Principle • Mycosel Agar are supplied by the peptone as a nutrition source prepared from soybean meal. • Dextrose is an energy source for the metabolism of fungi. • Cycloheximide inhibits most saprophytic molds. • Chloramphenicol is a broad spectrum antibiotic which inhibits a wide range of gram-positive and gram-negative bacteria.

• Aspergillus and Scopulariopsis are opportunistic pathogens. Cycloheximide will prevent their growth. Bacteria-like fungi (such as Actinomycetes) are inhibited by chloramphenicol. • Brain heart infusion slant (BHI) - more enriched than Sab-Dex. For recovery of H. capsulatum. • Potato-dextrose agar (PDA) and Corn-meal agar - used in slide cultures to induce spore formation, which aids in identification.

Preparing from commercial medium powder Commercial PDA Powder (20 gm dextrose, 15 gm agar, and 4 gm potato starch) 39 gm Distilled water 1 liter Preparing ourself Potato infusion 200 gm Dextrose 20 gm Agar 20 gm Distilled water 1 liter Procedure: 1. To prepare potato infusion, boil 200 g sliced, unpeeled potatoes in 1 liter distilled water for 30 min. 2. Filter through cheesecloth, saving effluent, which is potato infusion (or use commercial dehydrated form). 3. Mix with Dextrose, Agar and Water and boil to dissolve. 4. Autoclave 15 min at 121°C. 5. Dispense 20 -25 ml portions into sterile 15 × 100 mm petri dishes.

• Principle of Potato Dextrose Agar (PDA) • Potato Dextrose Agar is composed of dehydrated Potato Infusion and Dextrose that encourage luxuriant fungal growth. • Agar is added as the solidifying agent. • Many standard procedures use a specified amount of sterile tartaric acid (10%) to lower the p. H of this medium to 3. 5 +/- 0. 1, inhibiting bacterial growth. • Chloramphenicol acts as a selective agent to inhibit bacterial overgrowth of competing microorganisms from mixed specimens, while permitting the selective isolation of fungi.

Special Culture media • Caffeic Acid Agar - Cryptococcus neoformans will produce melanin resulting in black colonies (must protect media from light). Ingredients Gm/L Yeast extract 2. 0 g Dextrose 5. 0 g Agar 20 g Magnesium sulphate 0. 7 g Caffeic acid 0. 18 g Ferric citrate 0. 02 g Final p. H ( at 25°C) 6. 5± 0. 2 Ammonium sulphate Dipotassium phosphate 5. 0 g 0. 8 g

• Principle • The medium contains caffeic acid which is a selective agent for C. neoformans. • Caffeic acid is an O-diphenol compound which can be oxidized by phenoloxidase enzyme to produce dark brown melanin pigmentation. • C. neoformans has a unique ability to produce melanin or melanin like pigment from pand o-diphenols and can be differentiated from Candida albicans. • Thus, Caffeic acid causes pigment production of C. neoformans in the presence of (iron) ferric citrate.

• Dextrose is the fermentable carbohydrate in the medium while yeast extract serves as the source of nitrogenous nutrients and B vitamins. • Sulphates and phosphate buffer the medium. • Ferric citrate aids in pigment production by C. neoformans in the presence of caffeic acid. • Chloramphenicol, if added, inhibits the accompanying bacterial flora.

• Birdseed Agar - used to isolate Cryptococcus neoformans from contaminated cultures. Composition of media Ingredients Guizotia abyssinica seeds Creatinine Dextrose Chloramphenicol Agar Gm / Litre 70 g 0. 780 g 10 g 0. 050 g 20 g

• The extract of Guizotia abyssinica seeds contains caffeic acid. • Phenoloxidase enzyme produced by Cryptococcus neoformans utilizes caffeic acid as a substrate and produces melanin which in turn is absorbed by the yeast cell wall forming a tan to reddish-brown pigmentation. • Glucose is the energy source in the medium. • Creatinine enhances melanization of some strains of Cryptococcus neoformans. • Agar is the solidifying agent. • Chloramphenicol is added to inhibit the growth of bacteria and fast-growing fungi.

* KT Medium & Kelley Agar • - used to convert dimorphic fungus Blastomyces dermatitidis from mycelial to yeast form. *Modified Converse Liquid Medium (Levine's) used to promote spherule production by Coccidioides immitis.

Fungal growth requirements • Temperature - room temperature (25 -30 °C. ) for most fungi. –Nocardia sp. and some dimorphic organisms grow best at 37 °C. –Any fungus capable of growing at 37 °C, should be considered potentially pathogenic. • Atmosphere - True fungi are aerobic but there a few anaerobes among the bacteria-like fungi. • Dimorphic fungi are fungi which can exist as mold filamentous form or as yeast. • At room temperature, it grows as a mold. • At body temperature, it grows as a yeast.

• Time - Some yeasts grow overnight. Saprophytes are fast growers (several days). Generally cultures are held at least 4 weeks. –Paracoccidioides brasiliensis may require 4 -5 weeks; 10 weeks are recommended if Histoplasma capsulatum is suspected.

- Slides: 19